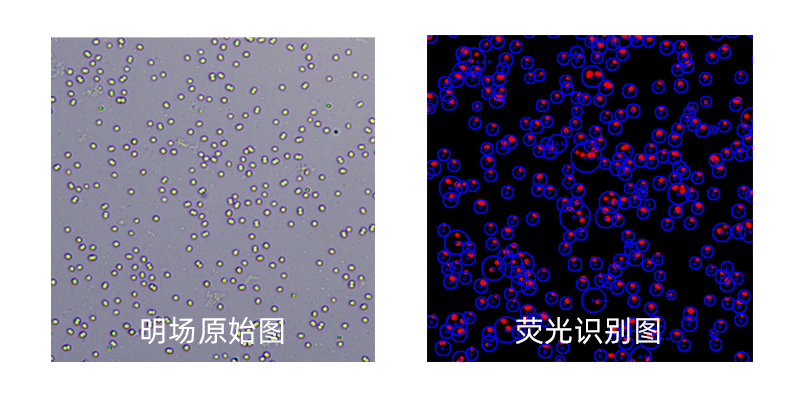

博大博聚-植物細胞計數儀憑借精準的光學識別與智能分析能力,可快速捕捉不同藻種的形態(tài)特征,實現細胞濃度與活性的高效量化。以下結合5種典型微藻的生物學特性,搭配儀器實拍圖展開解析。

假微型海鏈藻
為光合自養(yǎng)型硅藻,細胞體型較小。廣泛應用于基礎研究、水產養(yǎng)殖(作為餌料)領域,同時可用于生物質能開發(fā)。

威氏海鏈藻
是常見的海洋浮游硅藻,適應范圍較廣的鹽度環(huán)境。主要作為水產育苗的高營養(yǎng)餌料,其細胞計數結果可反映海域的營養(yǎng)狀態(tài)。

三角褐指藻
屬于硅藻類,存在卵形、梭形、三出放射形三種可轉變形態(tài),液體培養(yǎng)中以後兩種形態(tài)為主。適宜在鹽度25-32、溫度10-20℃的環(huán)境中生長,通過分裂方式繁殖,可作為魚蝦養(yǎng)殖的餌料。

銅綠微囊藻
為藍藻類,群體呈橄欖綠色或污綠色,單細胞呈球形(直徑3.0-7.0μm)。主要生活于淡水環(huán)境,在28-32℃條件下易大量繁殖形成水華,可產生肝毒性毒素,對水生物及人體健康存在影響。
小球藻
是單細胞綠藻,呈球形,直徑3-8μm,含葉綠素,具備光合作用能力。營養(yǎng)成分豐富,可通過光合作用自養(yǎng)生長,也可依賴外源營養(yǎng)異養(yǎng)生長;廣泛用于食品加工、飼料生產、生物柴油開發(fā),亦用于水質凈化。

儀器應用核心優(yōu)勢
形態(tài)適配性:可兼容不同形狀的藻類,通過智能算法優(yōu)化識別參數。
效率提升:單樣品計數時間≤1分鐘
場景多元:涵蓋基礎研究、生產應用及環(huán)境監(jiān)測等多領域需求。
通過以上案例可見,植物細胞計數儀不僅實現了微藻計數的精準化,更推動了相關研究與產業(yè)應用的標準化發(fā)展。